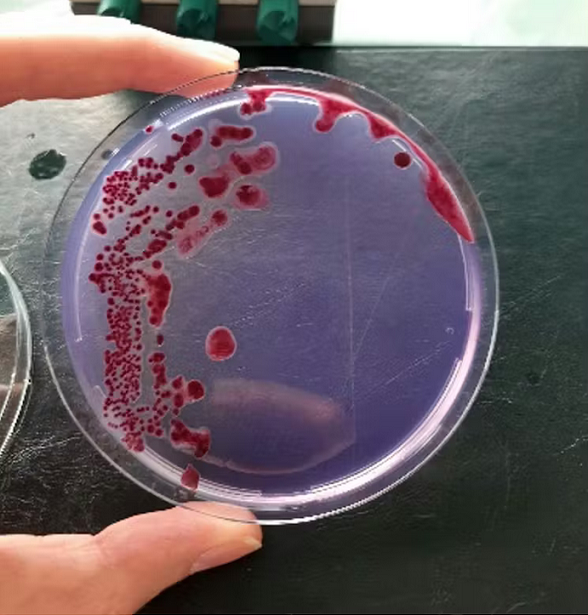

Blog / Conseils
Pourquoi il ne faut pas rapporter de végétaux de retour de voyage


Rapporter une bouture dans ses valises ou planter un gingembre acheté au supermarché, ces gestes qui semblent anodins peuvent favoriser l’arrivée d’organismes nuisibles – bactéries, virus, insectes, champignons… – capables de décimer les cultures, les plantes ornementales et les plantes sauvages. Sous les effets combinés de la mondialisation du commerce et des voyages et du dérèglement climatique, les risques se multiplient. L’Agence nationale de sécurité sanitaire de l’alimentation, de l’environnement et du travail développe des outils d’évaluation de risque et de détection, mais chacun peut agir à son niveau. De bonnes pratiques peuvent contribuer à protéger la santé des végétaux, dont dépendent notre alimentation ainsi que la biodiversité.
[Un article de TheConversation écrit par Christine Tayeh – Coordinatrice scientifique au Laboratoire de la santé des végétaux – Unité Expertise en Risques Biologiques pour la Santé des Végétaux (UERB), Agence nationale de sécurité sanitaire de l’alimentation, de l’environnement et du travail (Anses) & Amandine Cunty – Chargée de projet recherche Equipe Bactériologie, UBVO, Laboratoire de la santé des végétaux – Bacteriology team, UBVO, Plant health laboratory, Agence nationale de sécurité sanitaire de l’alimentation, de l’environnement et du travail (Anses)]
Saviez-vous qu’un voyageur imprudent pouvait ramener dans ses bagages des agents pathogènes aux conséquences dramatiques pour la santé des végétaux ? Espèces cultivées ou même flore sauvage, toutes sont potentiellement vulnérables. Il suffit d’un organisme nuisible (ON) – bactérie, virus, champignon, insecte ravageur, nématode ou même plante invasive – venu d’une autre région du monde pour les mettre en péril.

De fait, les échanges commerciaux internationaux constituent le plus souvent les voies « classiques » d’introduction de ces ON.
Citons, pour illustrer ces enjeux, l’exemple de Ficus microcarpa (ou laurier d’inde) une plante d’ornement couramment cultivée comme bonsaï en intérieur et régulièrement vendue en jardinerie et grandes surfaces. En 2023, Meloidogyne enterolobii, un nématode à galles polyphage (capable d’attaquer de nombreuses espèces), responsable d’importantes altérations de la morphologie et du fonctionnement du système racinaire, aurait été introduit en Toscane (Italie) sur des lauriers d’inde importés de Chine via les Pays-Bas.
Des voies d’entrée multiples
Les voies d’introduction les plus classiques impliquent par exemple le transport de végétaux, de semis, de fleurs coupées, ainsi que le résume l’illustration ci-dessous. Cependant, d’autres filières d’entrée moins conventionnelles existent également.

Dans les années 1940, le chancre coloré du platane (causé par le champignon Ceratocystis platani) a ravagé les plantations urbaines de platanes dans les grandes villes américaines de la côte atlantique. Pendant la Seconde Guerre mondiale, le bois des arbres infectés a été utilisé pour emballer du matériel de guerre. C’est probablement ainsi que l’ON a été introduit en Europe.
Cette hypothèse est confirmée par le fait que les premiers cas d’infection en Europe se trouvaient dans ou près des principales villes portuaires : Naples, Livourne, Syracuse, Marseille et Barcelone. À partir de celles-ci, la maladie s’est propagée dans d’autres villes.

Des rhizomes de gingembre importés du Pérou, destinés à la consommation humaine, ont véhiculé une bactérie nuisible en Allemagne, car ils ont été détournés pour être plantés sous serre. (Sur cette photographie, un gingembre sain.) Pixnio, CC BY-NC-SA
Un autre mode d’entrée possible pour un ON, est lorsque l’utilisation première d’un végétal est détournée.
Un cas avéré récent est celui de l’introduction en Allemagne de la bactérie Ralstonia pseudosolanacearum à l’origine du flétrissement bactérien sur de nombreuses cultures de la famille des Solanacées, dont la pomme de terre ou la tomate, mais également sur d’autres familles. Il est question ici de rhizomes de gingembre destinés à la consommation importés du Pérou, qui ont été détournés de leur usage principal car utilisés pour de la plantation.

Enfin, les voyageurs eux-mêmes sont aussi acteurs de l’entrée des ON sur un territoire. Entre 2016 et 2021, d’importantes quantités de produits végétaux ont été découvertes dans les bagages de voyageurs en provenance de pays tiers et saisies aux postes de contrôle frontaliers de Campanie en Italie. Des inspections et des analyses de laboratoire réalisées sur le matériel végétal ont permis d’identifier plusieurs espèces exotiques, dont certaines très alarmantes comme Bactrocera dorsalis (mouche orientale des fruits), également très polyphage.
Vers une probable accélération des introductions
Ces introductions sont favorisées par plusieurs facteurs de risque. Une augmentation de leur nombre est à craindre dans les années à venir, du fait de :
– l’intensification des échanges commerciaux internationaux de végétaux,
– l’accroissement des flux de voyageurs à travers le monde,
– la rapidité des transports (par avion, par exemple) qui améliore le taux de survie des ON,
– enfin, le dérèglement climatique, qui peut favoriser l’établissement des ON ou de leurs vecteurs dans nos régions tempérées devenues plus chaudes.
Autant de menaces accrues qui pèsent sur la santé des végétaux. Pour la défendre, il faut disposer d’outils innovants (évaluation du risque et méthodes de détection) et collaboratifs, et les mettre à disposition des acteurs en charge de l’évaluation et de la gestion des risques pour mieux les anticiper.
Or, avant qu’un ON puisse attaquer des végétaux sur un territoire donné, il faut qu’il soit en mesure d’entrer sur le territoire, de s’y établir puis se disséminer.
La détection des menaces et l’anticipation des risques à l’Anses
À l’Agence nationale de sécurité sanitaire de l’alimentation, de l’environnement et du travail (Anses), c’est l’unité Expertise sur les risques biologiques (ERB) qui mène des évaluations du risque selon les normes internationales pour les mesures phytosanitaires, ou NIMP02. Cet outil, utilisé en routine, est d’autant plus efficace qu’il peut être déployé avant l’arrivée d’un ON sur le territoire français.
Dans ce cadre, à partir des publications scientifiques et des données disponibles sur l’ON, on étudie en premier lieu la probabilité qu’il arrive dans une zone géographique donnée. L’organisme peut ensuite s’établir, c’est-à-dire se multiplier et créer de nouvelles générations.
Deux facteurs peuvent limiter cet établissement : la disponibilité de plantes hôtes et l’adéquation du climat localement. Mais une fois l’ON bien établi sur place, il peut se disséminer de façon plus large.

Les impacts directs d’un ON peuvent être des pertes de rendement et de qualité des récoltes ou des pertes de peuplements. D’autres impacts environnementaux, économiques et même sociétaux sont à envisager. On se souvient par exemple des ravages causés par l’arrivée de Xylella fastidiosa en Italie (sur les oliviers) et en Espagne (sur les amandiers), dont l’impact socio-économique est élevé.
En absence de mesures de lutte efficaces disponibles (lutte chimique, lutte génétique, pratiques culturales ou biocontrôle) et avec une probabilité d’introduction et de dissémination hautes, le risque lié à cet ON est considéré comme suffisamment élevé pour que des mesures de gestion soient recommandées. Elles visent à prévenir son entrée sur le territoire français, réduire son établissement (éradication), voire à enrayer sa dissémination, si celle-ci a déjà commencé.
À titre d’exemple, l’Anses a publié le 3 février 2020 une évaluation de risque sur le Tobamovirus fructirugosum, ou Tomato brown rugose fruit virus (ToBRFV), un virus émergent qui, à l’époque, menaçait la culture des tomates, piments et poivrons en France. Le rapport a conclu à une probabilité haute d’introduction et de dissémination en France, avec un impact conséquent sur les cultures. Différentes recommandations ont été émises et ont permis au gestionnaire du risque, qui est le ministère de l’agriculture et de la souveraineté alimentaire, de réagir rapidement à l’apparition du premier foyer en février 2020, et d’émettre des instructions techniques destinées aux professionnels, fondées sur des éléments d’analyse produits dans le rapport d’expertise.
Plus récemment, en juin 2025, l’Anses a produit une évaluation de risque sur la probabilité d’entrée et d’établissement de R. pseudosolanacearum (bactérie qui menace de nombreuses solanacées, comme la pomme de terre, la tomate ou le poivron) en France.
Plus récemment, en juin 2025, l’Anses a produit une évaluation de risque sur la probabilité d’entrée et d’établissement de R. pseudosolanacearum (bactérie qui menace de nombreuses solanacées, comme la pomme de terre, la tomate ou le poivron) en France.
Celle-ci a notamment permis, grâce à une analyse multicritères, de lister une quarantaine de plantes (bien plus large que la seule famille des solanacées) à inclure dans le plan de contrôle aux frontières. On y retrouve des espèces de la famille des zingibéracées (curcuma, gingembre y compris ceux destinés à la consommation) ainsi que des espèces ornementales (boutures et plants de rosiers et de pélargonium).
Le laboratoire de la santé des végétaux (LSV) de l’Anses exerce également des missions de laboratoire national de référence (LNR) sur des ON des végétaux (bactéries, virus, nématodes, insectes et acariens, oomycètes et champignons), sur des plantes invasives ou encore la détection d’OGM (par exemple, maïs, pommes de terre ou betteraves OGM) soumis à des réglementations européennes. À ce titre, le LSV développe et améliore des méthodes de détection/identification d’ON et participe à la formation et au suivi de compétence d’un réseau de laboratoires agréés pour réaliser des analyses officielles.
Afin d’anticiper au mieux de futures émergences d’ON réglementés qui ne seraient pas encore arrivés sur le territoire, le LSV recense les méthodes de détection/identification publiées au sein de la communauté scientifique, de l’Organisation européenne pour la protection des plantes (OEPP) ou de la Communauté internationale de protection des végétaux (CIPV). Le LSV va ensuite évaluer et valider ces méthodes selon des critères de performance bien définis (spécificité, sensibilité, limite de détection, répétabilité et reproductibilité) pour pouvoir les mettre en application le jour où l’ON ciblé serait détecté sur le territoire.
Le LSV a pu anticiper l’arrivée de Xylella fastidiosa dès le début des années 2000, par l’évaluation et la validation d’une méthode d’analyse. Ceci a permis au LNR d’être réactif dès les premiers échantillons reçus en 2015. Cette méthode évolue continuellement en fonction des avancées technologiques, nous en sommes à la version 6 ! À ce jour plus de 7 500 échantillons végétaux ont été analysés pour la recherche de Xylella fastidiosa dont la gamme d’hôtes inclut plus de 700 espèces végétales (olivier, amandier…).
En plus de ces missions, le LSV produit aussi des outils et des connaissances au service de l’évaluation et de la gestion du risque. Il s’agit de disposer d’une meilleure compréhension de la biologie de l’ON ainsi que de son épidémiologie en retraçant les routes d’invasions, et en identifiant l’origine géographique de l’introduction et les filières d’introduction. Les données acquises permettent de mieux comprendre leur dissémination, les facteurs favorisant leur développement (facteurs agronomiques, climatiques, géographiques…).
Les travaux menés par ces différentes entités au sein du LSV s’alimentent et se complémentent dans le but d’anticiper et limiter l’entrée et la dissémination d’ON sur le territoire. Mais la santé des végétaux est l’affaire de tous, celle des citoyens et des consommateurs : en vous inspirant des exemples décrits plus hauts, ayez le réflexe de ne pas rapporter de végétaux de retour de voyage et de ne pas planter des végétaux importés et destinés à la consommation alimentaire.
Source : https://www.science-et-vie.com/
